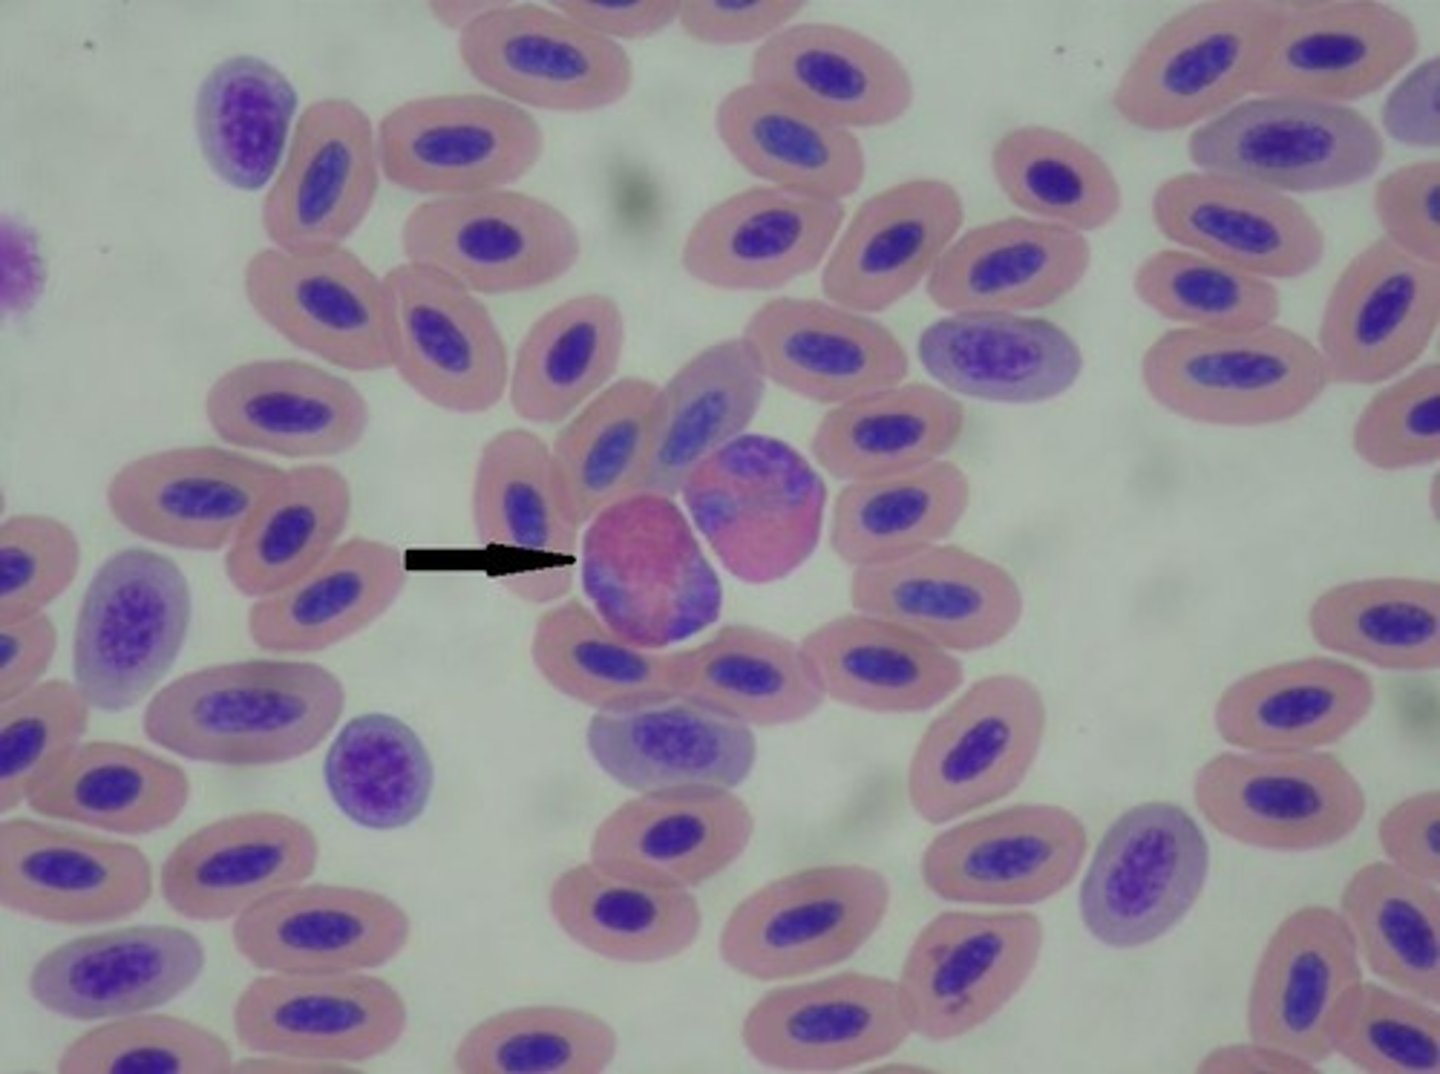
knowt flashcard image
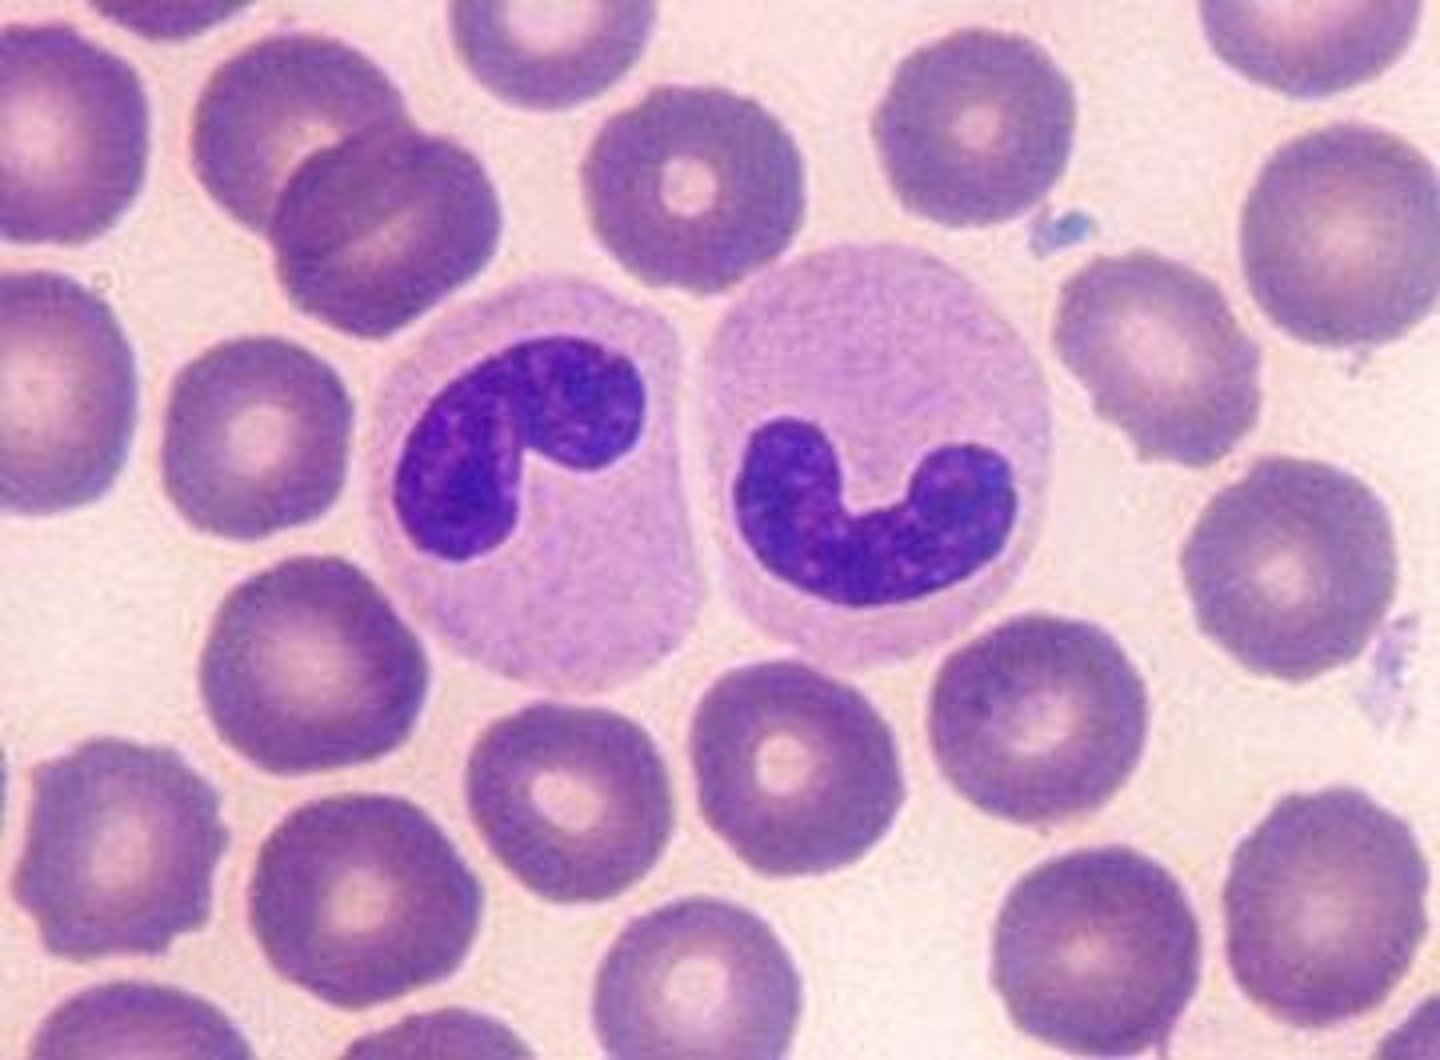
knowt flashcard image
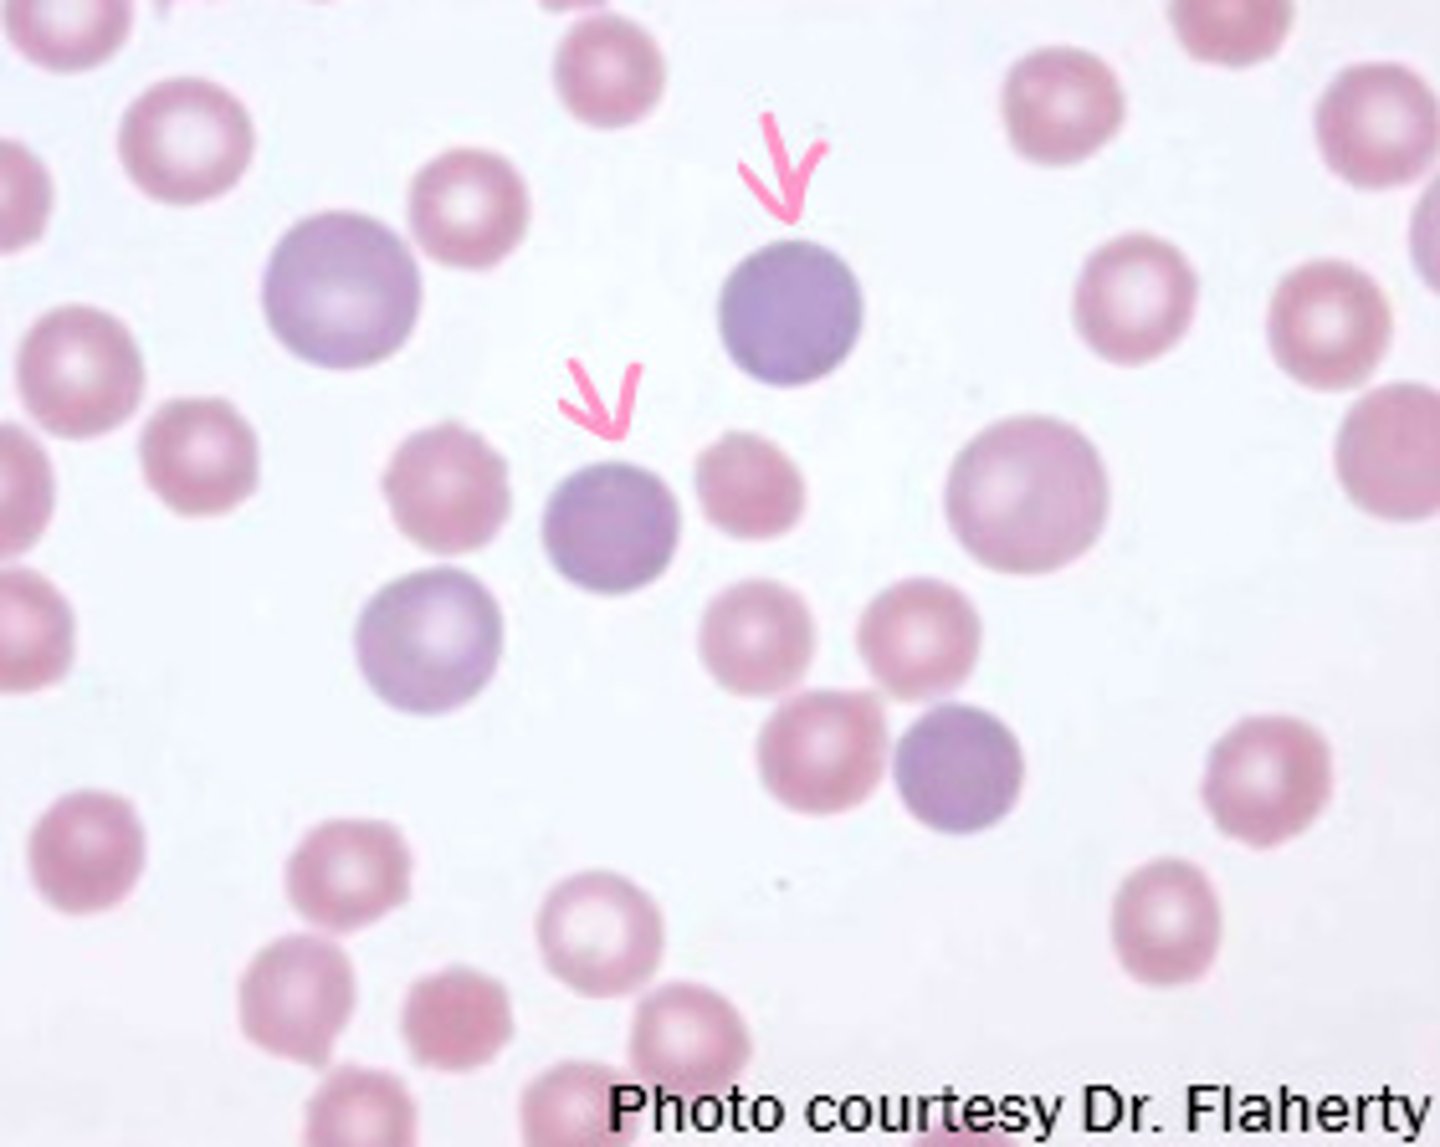
<p>Abnormally colored RBCs</p>
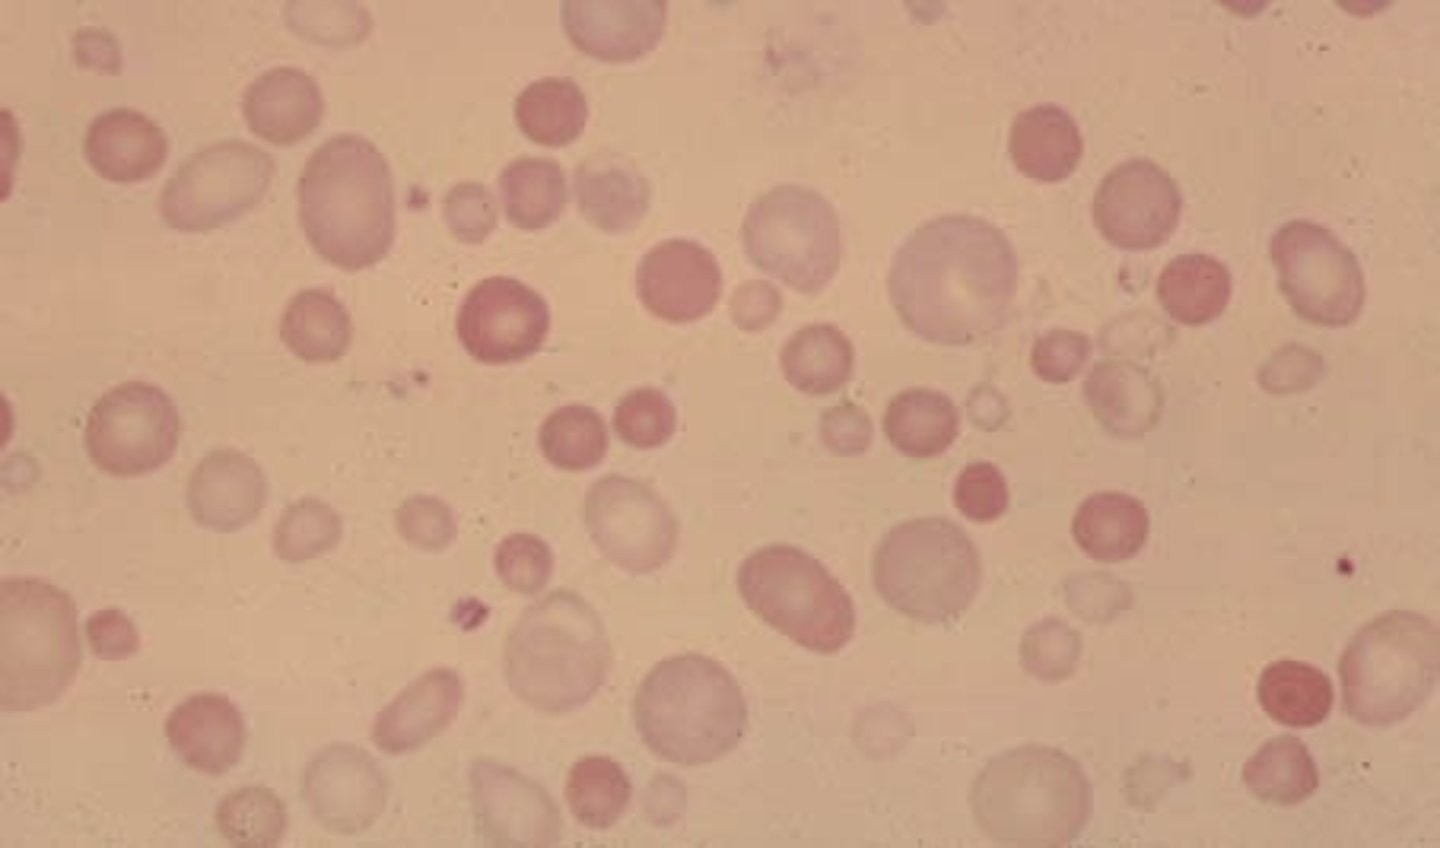
<p>Abnormal RBC size</p>
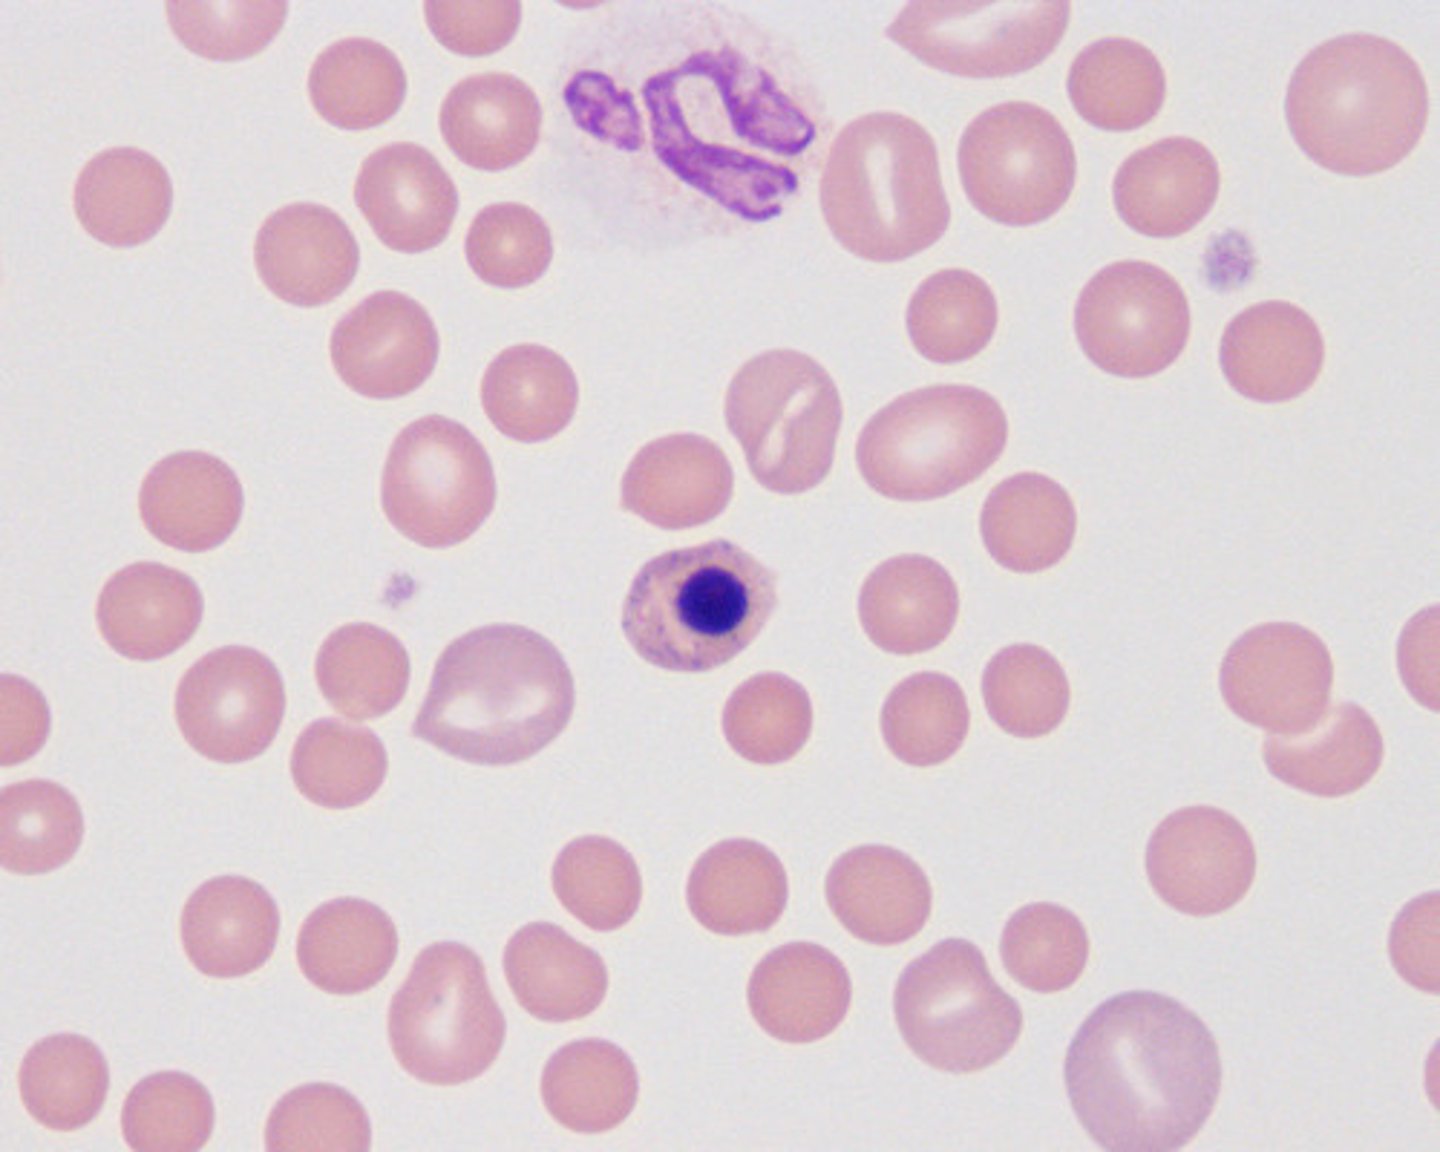
knowt flashcard image
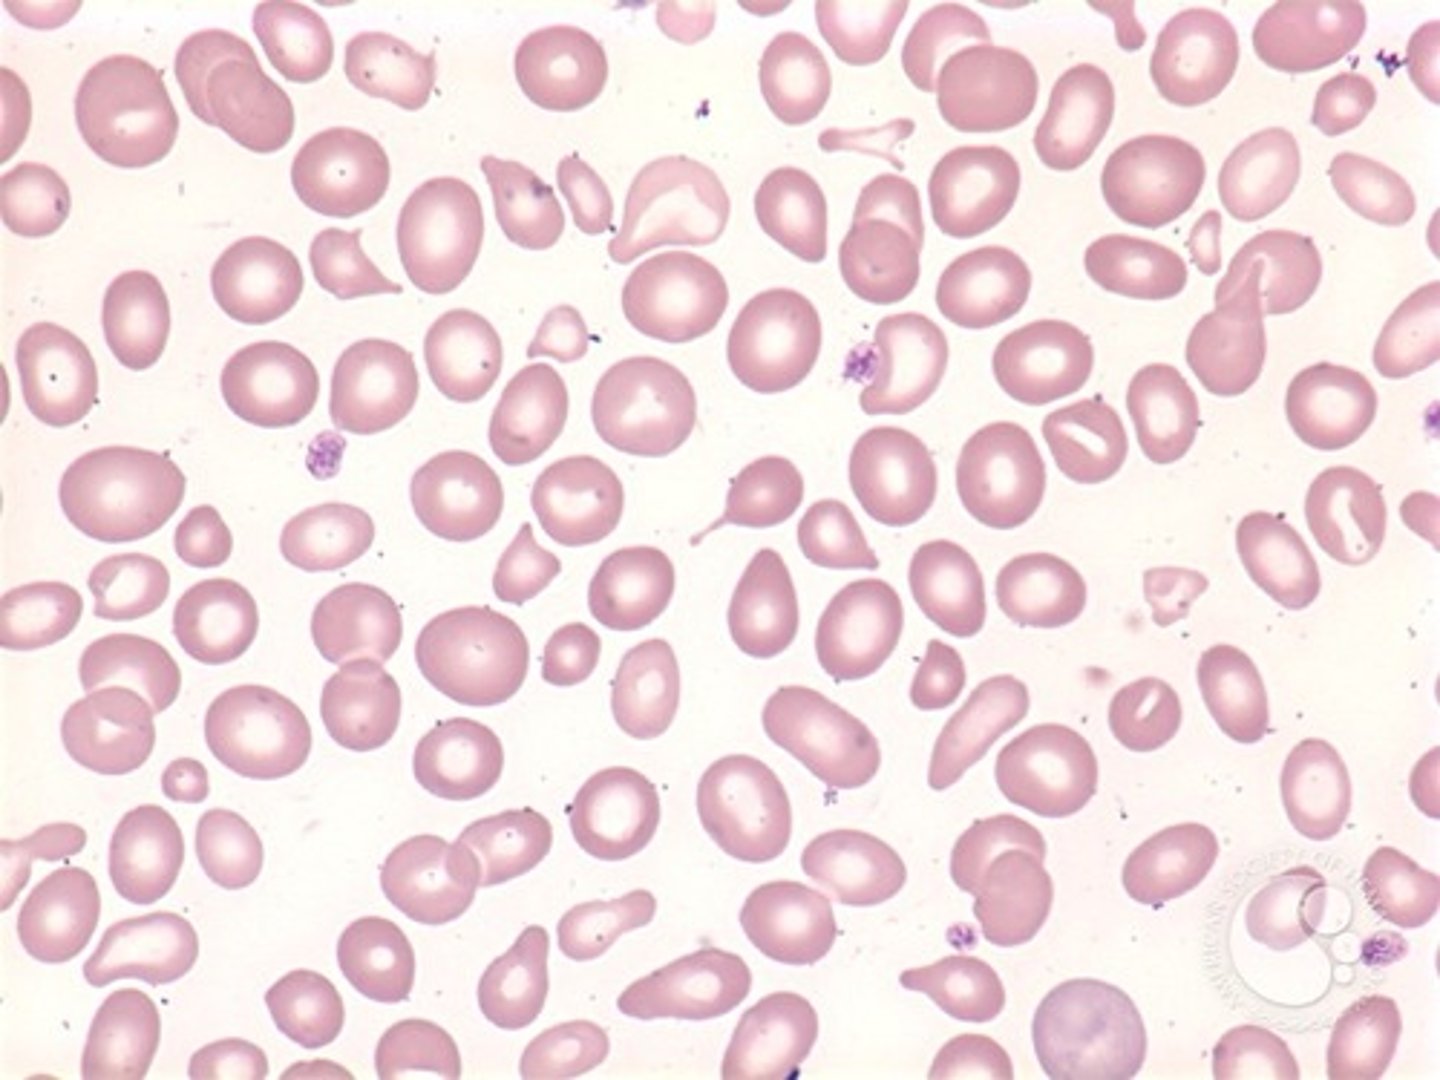
<p>Variation in shape of RBCs</p>
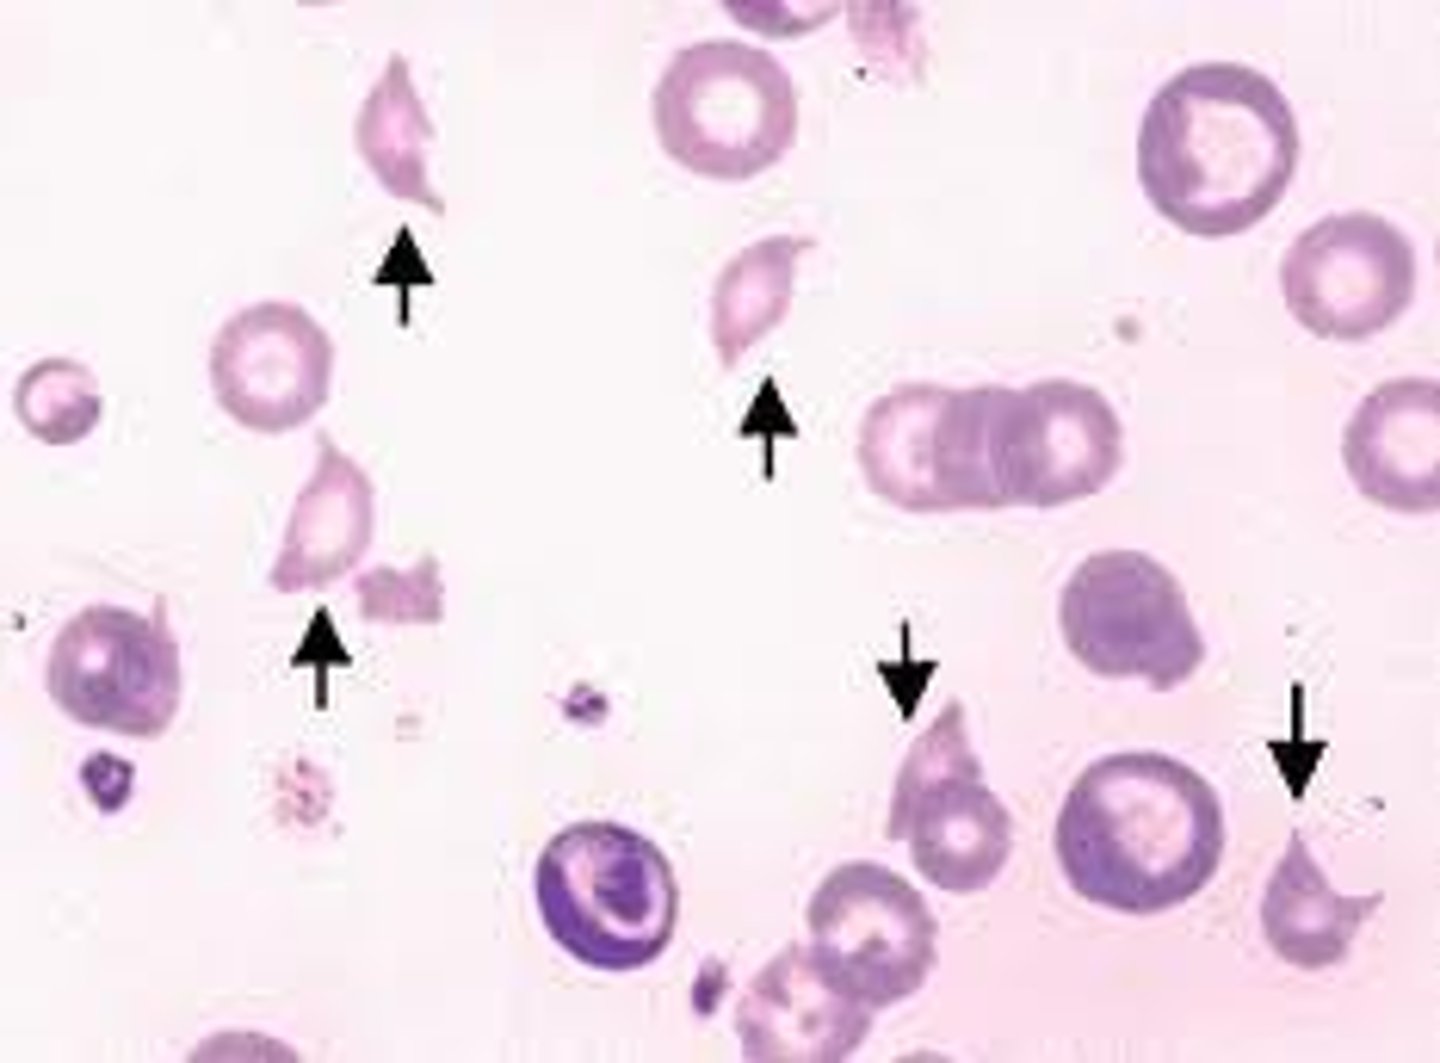
knowt flashcard image
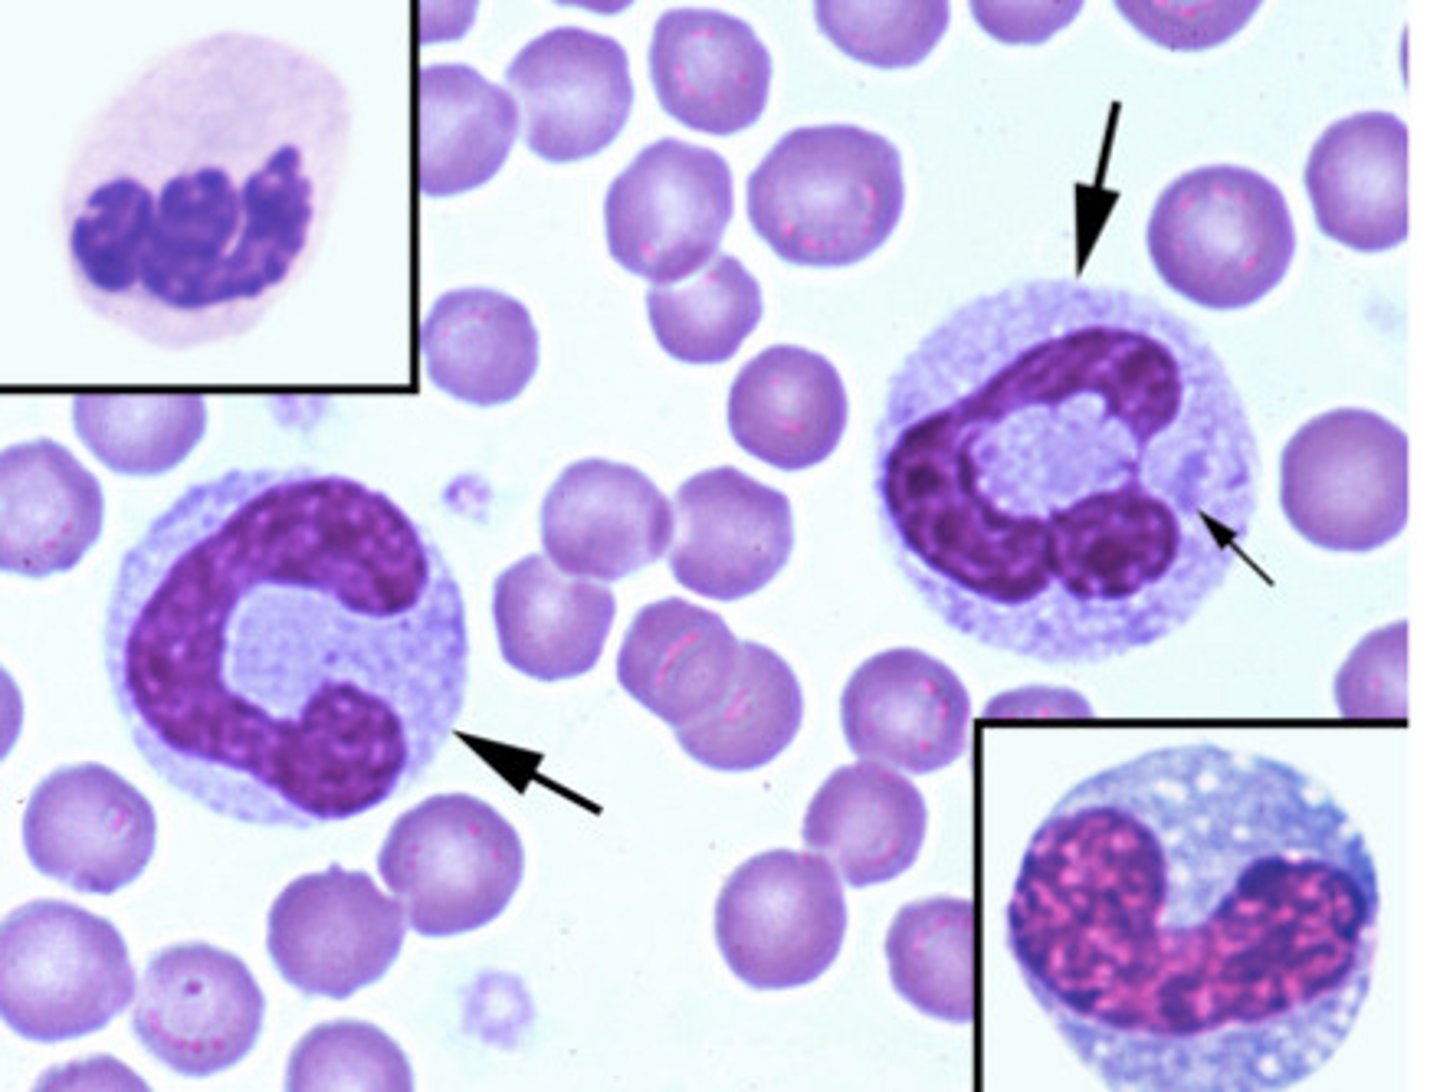
knowt flashcard image
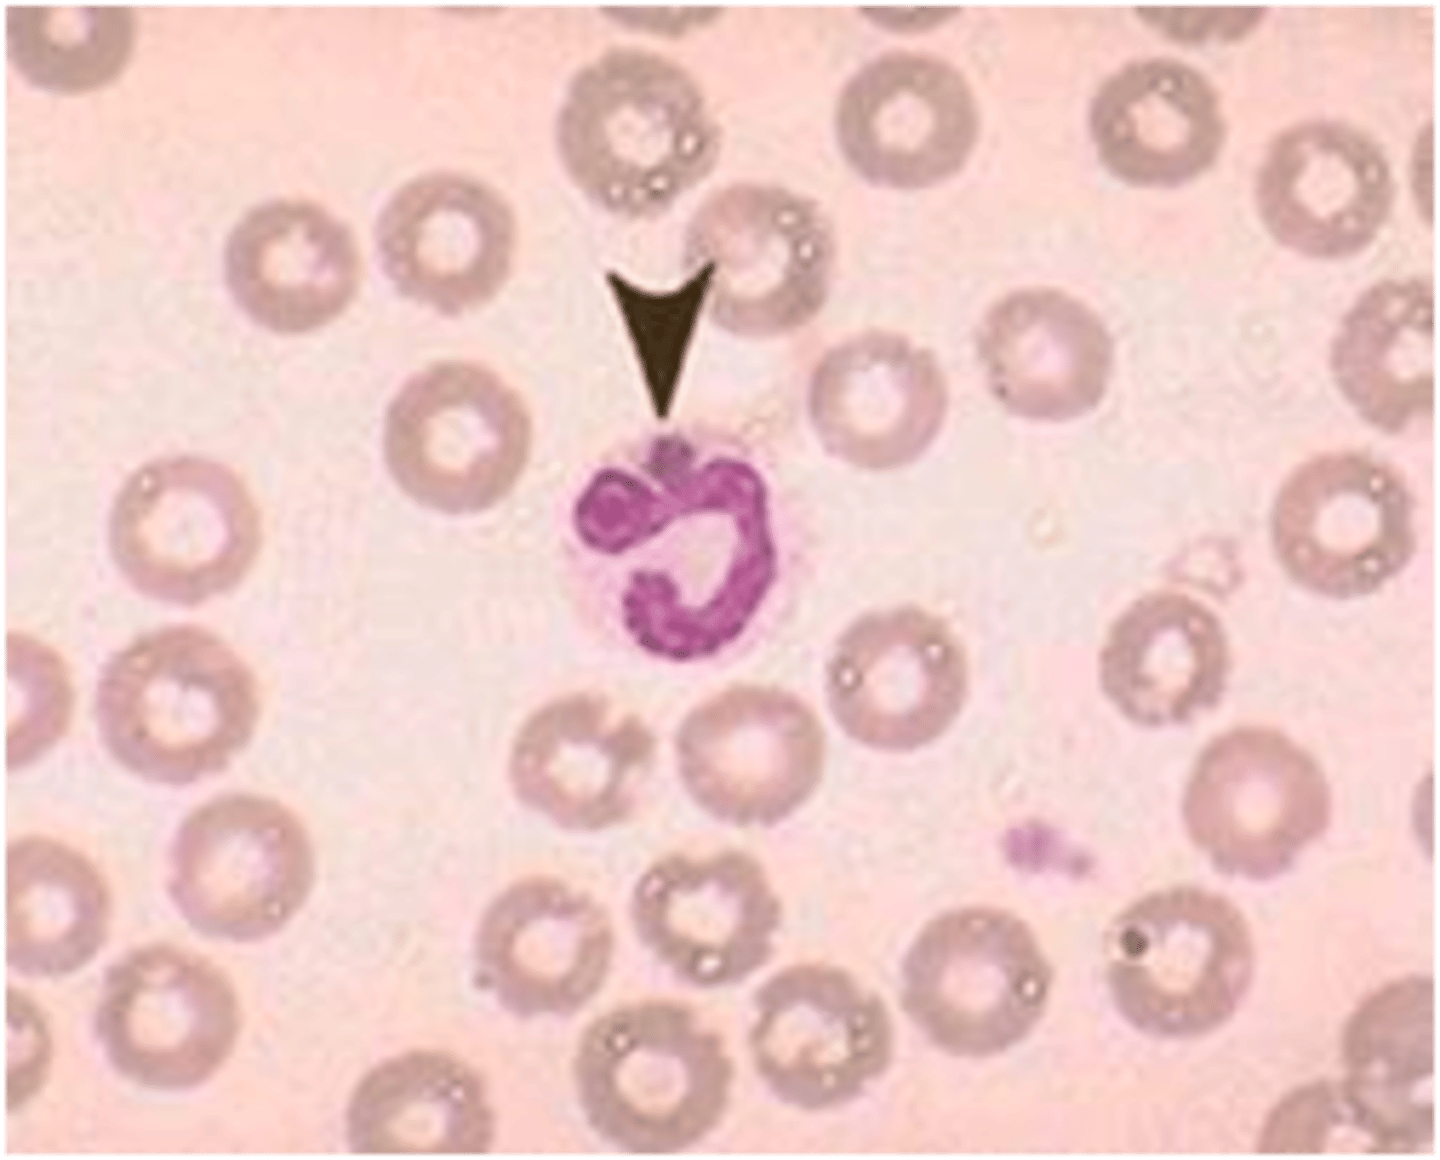
knowt flashcard image

1/31
Looks like no tags are added yet.
Name | Mastery | Learn | Test | Matching | Spaced | Call with Kai |
|---|
No study sessions yet.
Neutrophil

Heterophil
Band Neutrophil
Eosinophils

Basophil

Lymphocyte

Monocyte

Platelets

Polychromasia
Abnormally colored RBCs
Anisocytosis
Abnormal RBC size
Nucleated RBC
Leptocyte

Poikilocytosis
Variation in shape of RBCs
Echinocyte

Acanthocytes

Stomatocyte

Schistocyte
Rouleaux

Agglutination

Spherocytes

Heinz Bodies
Diff kwik stain

Howell-Jolly Body
Diff Kwik Stain

Babesia

Basophilic Stippling of a RBC

Mycoplasma Haemofelis

Toxic neutrophil
Dohle body

Erlichia
Reactive lymphocyte

Platelet clump

Microfilaria

Microfilaria